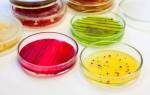

Существование нормальной кишечной микрофлоры – природный механизм защиты человеческого организма от целого ряда болезней, вызываемых бактериями. 99% бактерий, живущих в кишечнике, являются полезными. Они участвуют в окончательном переваривании пищи, поставляют некоторые витамины, а также успешно конкурируют с патогенной микрофлорой. Дисбактериозы, столь частые в наше время, побуждают людей искать лекарства, содержащие живые бактерии для пользы кишечника. Названия препаратов в данном случае мало о чем скажут непосвященному покупателю. Чтобы убедиться, что в их состав входят живые бактерии, нужно как минимум прочитать инструкцию-вкладыш. Попробуем разобраться с выбором подходящего препарата, объяснив механизм работы микрофлоры кишечника.
Прежде чем отправиться на поиски средств, содержащих живые бактерии, попробуем понять, какие у них имеются преимущества.
Взаимодействие кишечных жителей: условия и правила
Специалисты различают полезную и патогенную микрофлору кишечника. Патогенные бактерии очень редко обнаруживаются на фото просвета кишечника у здоровых детей и взрослых. Это связано с тем, что они составляют не более 1% микрофлоры кишечника здорового человека и редко попадают в кадр. Основными жителями кишечника являются бифидобактерии. На втором месте – лактобактерии или молочнокислые палочки. Кроме того, в состав микрофлоры входит кишечная палочка, энтерококки, пропионовокислые бактерии. Они появляются на первой неделе жизни детей. Окончательно состав микрофлоры устанавливается в кишечнике человека к 14 годам.
Живые бактерии кишечника взрослого человека могут весить до 2 кг. Те, которые способны вызывать различные заболевания, обычно находятся под строгим контролем и давлением со стороны полезных микроорганизмов. Их часто называют условно патогенными, так как неконтролируемое их размножение чревато развитием различных заболеваний.
К числу условно-патогенной микрофлоры кишечника относят бактерии, имеющие такие названия, как клостридиум, синегнойная палочка, протей. Это возбудители различных кишечных инфекций.
Изучение механизмов взаимодействия различных видов живых организмов кишечника позволило выяснить, что полезные микроорганизмы вырабатывают вещества, подавляющие вредные бактерии и грибы. Это антибиотики (реутерин, плантарицин, лактолин, лактацидин), антибактериальное вещество под названием лизоцим, перекись водорода.
Кроме веществ, поддерживающих состав нормальной микрофлоры кишечника, бактерии способны вырабатывать витамины группы В (их названия знакомы всем – рибофлавин, тиамин, фолиевая и никотиновая кислоты, пиридоксин), К, а также соединения, улучшающие всасывание витамина Д.
Полезные живые бактерии кишечника способны вырабатывать серотонин, держать под контролем деление клеток слизистой, предотвращая появление опухолей, удалять из организма токсины, уменьшать содержание в крови холестерина.
Выбор препаратов живых бактерий для кишечника — задача, требующая внимательного подхода. Врачи подчеркивают, что не все пробиотики одинаково полезны. Название препарата может не отражать его реальную эффективность. Многие пациенты полагают, что любой пробиотик поможет улучшить пищеварение, однако это не всегда так. Важно учитывать состав, штаммы бактерий и их количество. Некоторые препараты могут содержать лишь небольшое количество активных микроорганизмов, что снижает их эффективность. Кроме того, разные штаммы могут оказывать различные воздействия на организм. Врачи рекомендуют консультироваться с гастроэнтерологами перед выбором пробиотиков, чтобы подобрать наиболее подходящий вариант, учитывающий индивидуальные особенности пациента и его состояние здоровья.

О пробиотиках, пребиотиках и поколениях
Лекарства от дисбактериоза делятся на две большие группы:
- Пробиотики. Это лекарства или пищевые продукты, содержащие живые бактерии или их споры, способные засевать кишечник.
- Пребиотики. Это вещества, вырабатываемые полезными микробами (например, молочная, уксусная, янтарная кислоты). Их основное действие состоит в создании благоприятных условий для развития собственной живой микрофлоры кишечника человека.
Независимо от того, к какой группе относятся лекарства, принимать их можно только по назначению врача!
Лекарства, содержащие полезные живые бактерии кишечника для взрослых и детей, делят на пять поколений в зависимости от их состава и свойств. Цена на лекарство обычно зависит от страны-производителя, состава и раскрученности торговой марки. Основой препарата чаще всего являются три бактерии, имеющие общие названия ацидофиллус (Acidophilus), бифидобактерии (Bifidobacterium) и болгарская палочка (Lactobacillus bulgaricus) . Многие штаммы с высокой эффективностью являются результатом работы генных инженеров. Они обычно неспособны длительное время жить в кишечнике и называются самоэлиминирующимися.
Первое поколение
Название препарата первого поколения чаще всего происходит от названия бактериальной монокультуры, входящей в его состав. Например, Лактобактерин, Бифидум- или Колибактерин (содержит эшерихию коли (Escherichia coli) – кишечную палочку), Бактисубтил (сокращенное от названия бактерии бациллюс субтилис (Bacillus subtilis)). Это один из наиболее доступных по цене вариантов, подходящих как для взрослых, так и для детей.
Выбор препаратов живых бактерий для кишечника вызывает множество обсуждений среди потребителей и специалистов. Многие люди обращаются к пробиотикам в надежде улучшить пищеварение, укрепить иммунитет и восстановить баланс микрофлоры. Однако не все понимают, что название препарата может не отражать его реальную эффективность. Часто на упаковках можно встретить громкие обещания, но важно учитывать состав, штаммы бактерий и их количество. Некоторые препараты могут содержать лишь небольшое количество активных культур, что снижает их полезные свойства. Кроме того, индивидуальная реакция на пробиотики может варьироваться: то, что подходит одному, может не подойти другому. Поэтому перед выбором стоит проконсультироваться с врачом и внимательно изучить информацию о препарате, чтобы сделать осознанный выбор.

Второе поколение
Сюда относят лекарства, состоящие из веществ, выделяемых микроорганизмами нормальной микрофлоры и имеющих способность создавать так называемую колонизационную резистентность (устойчивость нормальной микрофлоры к заселению условно патогенными микроорганизмами). Типичные лекарства имеют знакомые названия – Хилак Форте или Нукс-Вомика Гомаккорд.
Третье поколение
Действие препарата третьего поколения состоит в засевании кишечника взрослых или детей микрофлорой, антагонистичной к патогенной. Бактерии, входящие в состав таких лекарств, не могут постоянно заселять кишечник и со временем самоэлиминируются его нормальной микрофлорой. Это например, такие названия, как Биоспорин, Споробактерин, Аципол или Энтерол.

Четвертое поколение
Сюда относят препараты, в состав которых входит несколько штаммов полезных живых микробов. Они могут быть как самоэлиминирующимися, так и постоянно живущими в кишечнике. Примеры названий – Линекс, Бифилонг, Бифипол.
Пятое поколение
Эти лекарства содержат культуры полезных микроорганизмов и вещества, ускоряющие процесс восстановления микрофлоры. Весьма эффективны для детей, имеют быстро наступающий и продолжительный эффект.
Бактерии и детское питание
Грудное молоко – источник необходимых микроорганизмов для детей. Нарушения в составе микрофлоры во время грудного вскармливания чаще всего происходят при приеме матерью или малышом антибиотиков, а также при стрессах или жизни в неблагоприятных экологических условиях.
Если же ребенок растет на искусственном вскармливании, пробиотики должны обязательно входить в состав его рациона. Готовые сухие смеси для детей должны содержать бифидо- и лактобактерии, кроме того, бактериальные препараты с перечисленными названиями могут назначаться дополнительно.
Лекарства или йогурты?
Кроме многочисленных и весьма недешевых аптечных препаратов, существует возможность самостоятельного приготовления препаратов живых бактерий из молока. Для этих целей выпускаются различные закваски, имеющие множество названий, способные превратить молоко во вкусный и полезный йогурт, кефир или ряженку.
Молоко неизвестного происхождения перед началом процедуры кипятят и остужают. Затем смешивают с закваской в указанной пропорции и ставят на ночь в теплое место. Удобно использовать йогуртницы, однако и стеклянная посуда также подходит. Несколько раз взбалтывают, чтобы обеспечить равномерное распределение микроорганизмов в молоке. Через 6-8 часов йогурт готов.
В зависимости от культур, входящих в состав закваски, можно получить продукт, обогащенный бифидо- или лактобактериями. Обычно бактериальный состав закваски соответствует ее названию. Некоторые таблетированные бактериальные препараты при смешивании с молоком позволяют получить результат, аналогичный порошковым закваскам. Полезно с раннего возраста приучать детей к регулярному приему препаратов, содержащих живые бактерии. Эта привычка сохранит их здоровье и увеличит продолжительность жизни.
Вопрос-ответ
Как выбрать подходящий пробиотик для своего кишечника?
При выборе пробиотика важно учитывать состав, количество живых бактерий и их штаммы. Рекомендуется выбирать препараты с хорошо изученными штаммами, которые имеют доказанную эффективность для решения конкретных проблем, таких как дисбактериоз или улучшение пищеварения. Также стоит обратить внимание на срок годности и условия хранения, чтобы гарантировать сохранность живых бактерий.
Как часто нужно принимать пробиотики для достижения эффекта?
Частота приема пробиотиков зависит от конкретного препарата и рекомендаций врача. Обычно курс приема составляет от нескольких недель до нескольких месяцев. Для поддержания здоровья кишечника многие специалисты рекомендуют принимать пробиотики регулярно, особенно после курса антибиотиков или в периоды стресса.
Могут ли пробиотики вызывать побочные эффекты?
Хотя пробиотики обычно считаются безопасными, у некоторых людей могут возникать побочные эффекты, такие как вздутие живота, газообразование или легкие расстройства пищеварения. Эти симптомы обычно проходят через несколько дней. Если побочные эффекты сохраняются или усиливаются, рекомендуется проконсультироваться с врачом.
Советы
СОВЕТ №1
Перед выбором пробиотиков внимательно изучите состав препарата. Обратите внимание на конкретные штаммы бактерий, так как разные штаммы могут оказывать различное влияние на здоровье кишечника. Ищите научные исследования, подтверждающие эффективность выбранных штаммов для вашей проблемы.
СОВЕТ №2
Проконсультируйтесь с врачом или диетологом перед началом приема пробиотиков. Специалист поможет определить, какие именно препараты подойдут вам, учитывая индивидуальные особенности вашего организма и возможные противопоказания.
СОВЕТ №3
Обратите внимание на условия хранения пробиотиков. Некоторые препараты требуют хранения в холодильнике, чтобы сохранить активность живых бактерий. Убедитесь, что вы соблюдаете рекомендации производителя для достижения максимального эффекта.
СОВЕТ №4
Не забывайте о важности комплексного подхода к здоровью кишечника. Пробиотики могут быть полезны, но для достижения наилучших результатов сочетайте их с правильным питанием, физической активностью и достаточным уровнем гидратации.